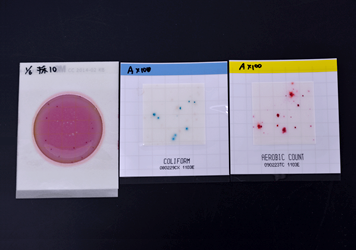
フィルム培地による細菌検査イメージ

地球規模で持続可能な社会の構築を考えてゆかなければならない時代の中で、企業にとっても、環境への取り組みは重要な経営課題のひとつとなっています。企業活動に対しては、さまざまな法律によって環境保全義務が課せられていますが、それらを遵守せずに環境を汚染した場合、法律によって罰せられるだけでなく、メディアなどを通じ広く世間に知られることによって、企業の信頼を失うことになりかねません。
私たちは、企業廃水や産業廃棄物などに対する信頼性の高い分析を通して、企業を取り巻くさまざまな環境の維持・改善のお手伝いをしています。
各種工場、大学、各種研究施設、病院、自治体、農業関連施設、漁業関連施設
水質汚濁防止法、下水道法、浄化槽法および各種条例などに基づく水質分析を行います。
【分析対象】
人の生活に欠かせない水道水、浴槽水、プール水、事業場廃水、工場廃水(原水・処理水)、生活廃水、下水道放流水、浄化槽廃水、工業用水、純水、農業用水、環境水(河川水、海水など)、地下水、その他
【分析項目・機器】
*別表(PDF)を参照
上水
廃水
環境水

重金属測定のための溶媒抽出

高速液体クロマトグラフ装置
WET(全排水毒性)評価は、排水における多様な化学物質の毒性の有無を総合的に評価し、一律排水規制を補完する方法として近年注目されています。そのひとつの方法であるバイオアッセイ(Bioassay)とは、処理水で魚などの水生生物を飼育し、その応答から処理水中の化学物質の複合的な影響を評価するという方法です。
弊社では、自ら排水処理を行っている工場や研究施設などに対して、室内のバイオアッセイ水槽による評価やビオトープ池(バイオアッセイ池)による評価を提案しています。
これらは、廃水処理水の安全性を確認できるだけでなく、環境への取り組みを視覚的にアピールできるため、企業イメージのアップにもつながるという付加的なメリットを生み出します。

バイオアッセイ水槽

ビオトープ池
土壌汚染対策法、産業廃棄物の処理基準、肥料取締法および各種条例に基づいた、固型廃棄物・土壌分析・肥料(堆肥)分析を行います。同時に、土壌・肥料研究のサポートも行います。
【分析対象】
燃え殻、汚泥、廃油、廃酸、廃アルカリ、廃プラスチック類、紙くず、木くず、繊維くず、ゴムくず、金属くず、ガラス・コンクリートくず、鉱さい、がれき類、動物性残さ、動物系固形不要物、家畜のふん尿、コンポスト、その他
弊社では、水・汚泥・土壌などのさまざまな環境サンプルについて、培養に依存しない分子生物学(遺伝学)的手法を用い、環境微生物群集構造の変化のモニタリング、存在している微生物種の推定、目的とする微生物を検出するためのPCRプライマー、オリゴヌクレオチドプローブの設計などを受託しています。

DGGE電気泳動装置

DGGE泳動バンドパターン
厳密な定量を必要とせず、栄養塩類、有害物質や重金属などの有無を知りたい場合や、定量分析を行うかどうかとりあえずスクリーニングを行いたい場合などには、低コストで迅速な簡易分析を用意しています。

パックテストによる水質測定
フィルム培地による細菌検査

薬品管理システムによる試薬登録
さまざまな化学物質や薬品を取り扱う企業や研究施設・大学などにおける、試薬管理をトータルにサポートします。
「いつ」「誰が」「どの薬品を」「どれだけ」「何に」使用したかを記録できる薬品管理システムのご提案から、導入にあたってのサポート、実際の運用管理までを行います。また弊社の強みとして、使用済み薬品の廃棄管理とともに、その処理方法に至るまでをマニュアル化。各種法規制まで踏まえた安心・安全な試薬管理をバックアップします。

試験研究を進めていく上で必要になる未経験の分析のサポートを致します。
ニーズに合わせた分析方法の調査・立ち上げ、精度管理、測定までを行います。








